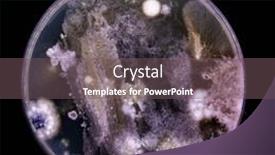
Presentation with culture - PPT theme featuring samples-of-petri-dishes background and a  colored foreground

247 Best Culture-Themed Templates for PowerPoint and Google Slides
Introducing Culture, a vast collection of 6.7 million PowerPoint templates that take you on a journey to explore the rich diversity of human culture around the world. This category is designed to inspire creativity and imagination, with over 4 dozen presentation titles that capture the essence of different cultures, from traditional handmade drums to vibrant Mexican sombreros.
Whether you're a student looking for inspiration or an professional seeking to elevate their presentation game, Culture has got you covered. The templates are compatible with Google Slides, ensuring seamless compatibility and collaboration across platforms. You'll find 60+ slides in total, including the title slide that sets the tone for your presentation, making it easy to customize and personalize.
Take a look at some of our stunning templates, each showcasing unique cultural elements such as tawny brown colored foregrounds with traditional handmade drum backdrops or hands in surgical glove holding petri dishes. Our templates are also available in both widescreen and standard formats, ensuring that you can easily find the perfect fit for your needs.
As a user, you'll appreciate the flexibility of Culture templates, which can be customized to suit your personal style. With instant 24/7 download access, you can start working on your presentation straight away. Explore our extensive collection and discover the perfect template to match your unique vision or browse through other categories for inspiration. Select the perfect template for your needs and elevate your presentation game today with CrystalGraphics Culture templates!
Features & Pricing
Widescreen (16:9) Presentation Templates. Change size...